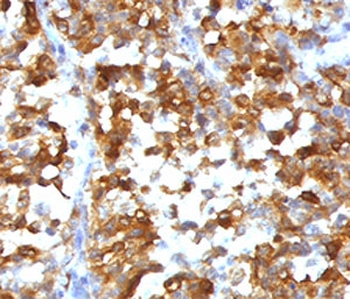
Recombinant MART-1 Antibody / Rabbit Monoclonal

You have no items in your shopping cart.
- Recombinant MART-1 Antibody / Rabbit Monoclonal [orb2641989]
IHC-P
Human
Rabbit
Recombinant
Unconjugated
100 μg - CD98 Rabbit Polyclonal Antibody (HRP) [orb468348]
ELISA, IHC-Fr, IHC-P
Guinea pig, Human, Mouse, Porcine, Rabbit, Rat
Rabbit
Polyclonal
HRP
100 μl - CD98 Rabbit Polyclonal Antibody (APC) [orb993362]
IF
Guinea pig, Human, Mouse, Porcine, Rabbit, Rat
Rabbit
Polyclonal
APC
100 μl